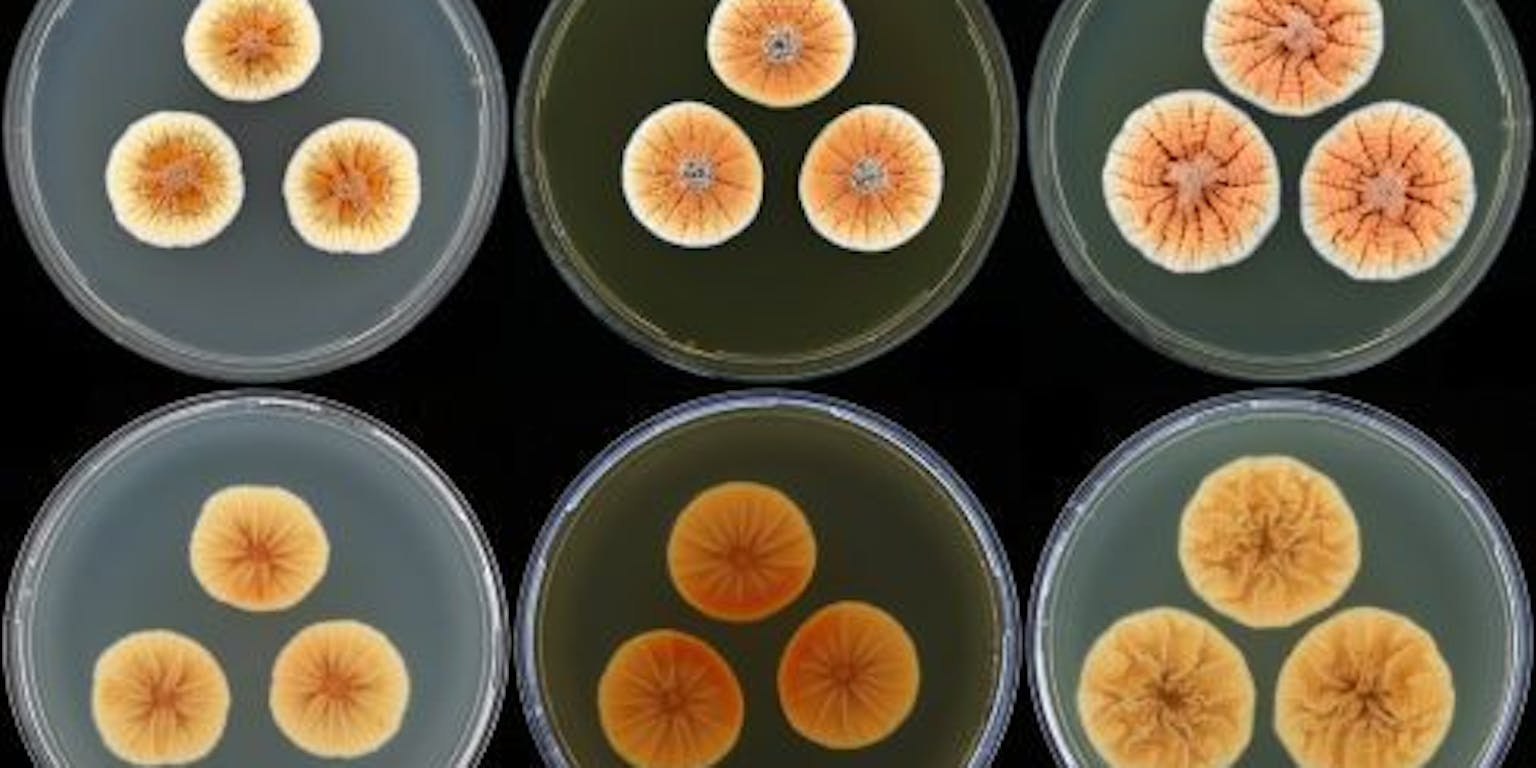

Hieronder zijn foto’s uit 2013 te zien die door de redactie als bijzonder bestempeld zijn.
Oranje schimmelfamilie krijgt koninklijk tintje (april 2013)
Onderzoekers van het Centraalbureau voor Schimmelcultures vernoemen een recent ontdekte oranjekleurige penicillium (penseelschimmel uit de familie van de penicilline) naar Willem-Alexander, Prins van Oranje. De schimmel draagt vanaf nu de naam Penicillium vanoranjei. Vier andere soorten penicillia die tot hetzelfde geslacht behoren en gelijktijdig ontdekt zijn, krijgen de toepasselijke namen Penicillium maximae, Penicillium amaliae, Penicillium alexiae en Penicillium arianeae. Of de koninklijke schimmels ook een geneeskrachtige werking hebben door bijvoorbeeld de productie van penicilline moet nog blijken.
Lees en bekijk meer over de oranje schimmels in de wetenschappelijke publicatie in het tijdschrift Persoonia.
Onder de grond van noord naar zuid Amsterdam (februari 2013)
Sinds 28 februari 2013 is het in principe mogelijk om de gehele afstand van 9,7 kilometer van de Noord/Zuidlijn in Amsterdam te voet af te leggen. Nadat de wand van station Rokin al eerder weg gehakt was, is nu ook de laatste doorbraak gerealiseerd met het verwijderen van het hoofdlager – het hart – van boormachine Molly.
Meer informatie vind je op de website hierzijnwijnu